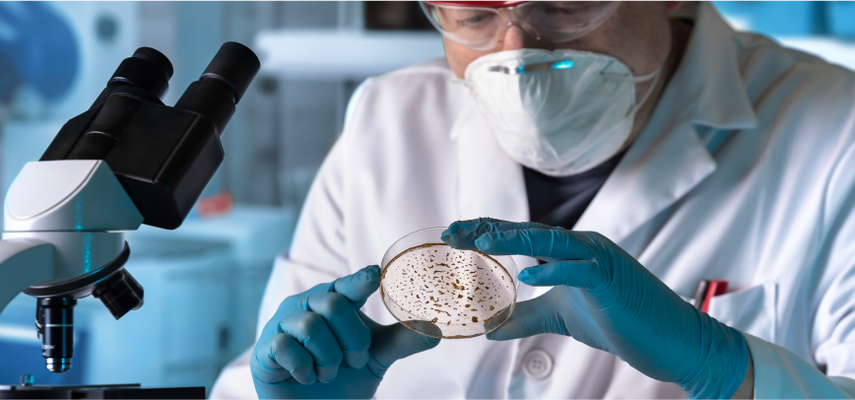
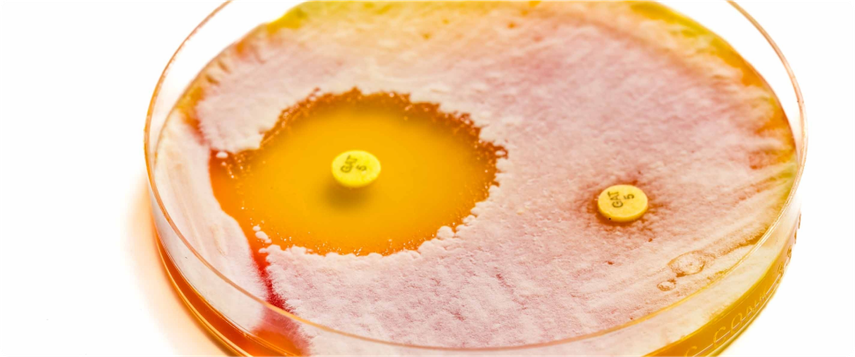
Image

Ahilova peta najopasnijih bakterija?
Podeli vest
Već decenijama, lekari se suočavaju sa sve većim problemom. To su infekcije, najčešće bolničke, koje su uzrokovane bakterijama koje su postale otporne na sve poznate antibiotike. To je posledica preširoke primene antibiotika čak i kada oni nisu potrebni. Smatra se da više od milion ljudi umire od infekcija bakterijama otpornih na lekove svake godine. Projekcije su još strašnije i očekuje se da će skoro 2 miliona ljudi umirati svake godine u narednih 25 godina.
Sada su se naučnici posvetili ispitivanju ovakvih bakterija tražeći rešenje za problem koji je sve veći. Oni su se fokusirali na bakteriju Bacillus subtilis, model organizma koji se obično koristi u laboratorijskim studijama. Njihovo istraživanje, objavljeno u naučnom časopisu “Science Advances”, motivisano je zbunjujućim pitanjem: Zašto se mutantne varijante bakterija koje razvijaju otpornost na antibiotike ne razmnožavaju i ne dominiraju populacijom bakterija? Ako posmatramo zakone evolucije, ove mutirane bakterije odnosno otporni sojevi bi trebalo da nadmaše druge sojeve te bakterije, jer su evoluciono naprednije, ali se u prirodnim uslovima to ne dešava. Zašto je tako?
Izgleda da otpornost na antibiotike daje bakterijama prednost u preživljavanju u prisustvu antibiotika, ali da to ima značajnu cenu. Naučnici tvrde da su pronašli Ahilovu petu bakterija otpornih na antibiotike koja ometa njihovu potencijalnu dominaciju. Istraga tima istraživača bila je usredsređena na ribozome — ćelijsku organelu odgovornu za sintezu proteina i prevođenje genetskih kodova. Ribosomi zahtevaju jone magnezijuma da bi održali svoju strukturu i funkciju. Kroz modeliranje na atomskoj skali, istraživači su otkrili da mutantni ribozomi, koji daju otpornost na antibiotike, pokušavaju da prekomerno preuzmu jone magnezijuma, što isto čine i molekuli adenozin trifosfata. Adenozin trifosfat je primarno energetsko jedinjenje u ćeliji, koje neophodno za obavljanje brojnih bioloških procesa. Ovo se dešava zbog ograničene količine magnezijumovih jona unutar ćelije. Studija je posebno ispitala varijantu ribozoma u Bacillus subtilis poznatu kao “L22”. Nalazi su otkrili da ovo takmičenje ometa rast mutanta L22 više nego kod nerezistentnih bakterija. Kao rezultat toga, bakterije otporne na antibiotike su fiziološki u nepovoljnom položaju u sredinama gde je magnezijum ograničen. Praktično, iako su zbog svoje rezistentnosti u povoljnijem položaju, nedostatak jona magnezijuma im ne dozvoljava da se razmnožavaju u velikom broju, te ne mogu da postanu dominantni soj te bakterije tokom vremena.
Ova “Ahilova peta” rezistentnih bakterija predstavlja novu metu za borbu protiv rezistencije na antibiotike. Manipulisanjem dostupnosti jona magnezijuma u sredinama gde se nalaze , možda je moguće selektivno inhibirati rast otpornih sojeva bakterija i time pomoći organizmu da se izbori sa bolešću. Naučnici već ciljaju helatne agense koji se mogu koristiti za izdvajanje jona magnezijuma, selektivno utičući na otporne bakterije.
Kako opasnost od infekcija otpornih na antibiotike raste, naučna zajednica se okuplja da pronađe efikasna rešenja. Razumevanjem i iskorišćavanjem slabosti otpornih bakterija, postoji nada za razvoj održivih intervencija koje mogu zaštititi zdravlje građana u budućnosti.
Podeli vest





